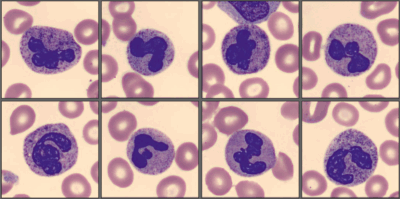
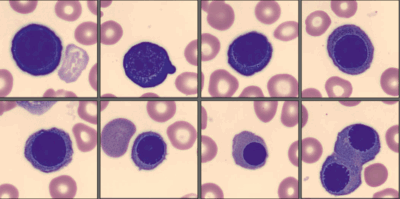

Paciente de 2 anos, sexo feminino, foi levada ao pediatra por seus pais devido a febre, fadiga, fraqueza, perda de peso e falta de ar. Eles também notaram pequenas manchas vermelhas na pele e hematomas com facilidade. O pediatra solicitou um hemograma completo. A análise do esfregaço foi realizada no CellaVision® DM-9600:


No software CellaVision® Remote Review, o analista de plantão pôde observar neutropenia com granulação tóxica, alguns linfócitos grandes granulares (LGLs), monócitos com aparência imatura e um número elevado de eritroblastos (NRBC) em diferentes estágios de maturação e com características displásicas. Ela também pôde observar um grande número de células imaturas grandes, com núcleos semelhantes aos de blastos, apresentando um ou mais nucléolos, citoplasma basofílico abundante com grânulos azurófilos finamente distribuídos e vacuolização. Algumas dessas células imaturas apresentavam núcleos dobrados e convolutos, com uma estrutura de cromatina delicada em forma de renda, e citoplasma azul acinzentado com grânulos azurófilos e vacúolos.

Citometria de fluxo: CD2-, CD4+, CD10-, CD11b+, CD14+, CD19-, CD22-, CD34+, CD64+, HLA-DR+.
Diagnóstico:
Leucemia monocítica aguda
Discussão:
A paciente foi diagnosticada com leucemia monocítica aguda. Os achados no software CellaVision® Remote Review permitiram que a equipe médica solicitasse os tipos corretos de exames de citoquímica, imuno-histoquímica, citometria de fluxo e testes moleculares.
A leucemia monocítica aguda é uma forma rara e agressiva de leucemia mieloide aguda (LMA) que envolve a linhagem monocítica.
É uma doença que pode ocorrer em todas as idades, representando aproximadamente 15 a 24% de todos os casos pediátricos de LMA e cerca de 3 a 6% de todos os casos diagnosticados de LMA. [1][2]
References:
[1] Marcogliese. AN., Haferlach. T., Nejati. E., Tembhare. PR. Acute myelomonocytic leukaemia. In: WHO Classification of Tumors series, 5th ed.; vol 11, IARC publications, https://publications. Iarc.who.int/637. 2024. p. 155-156.
[2] Varotto. E., Munaretto. E., Stefanchi. F., DellaTorre. F., Buldini. B. Diagnostic challenges in acute monoblastic/monocytic leukemia in children. Front Pediatr. 2022 Sep 28 doi: 10.3389/fped.2022.911093